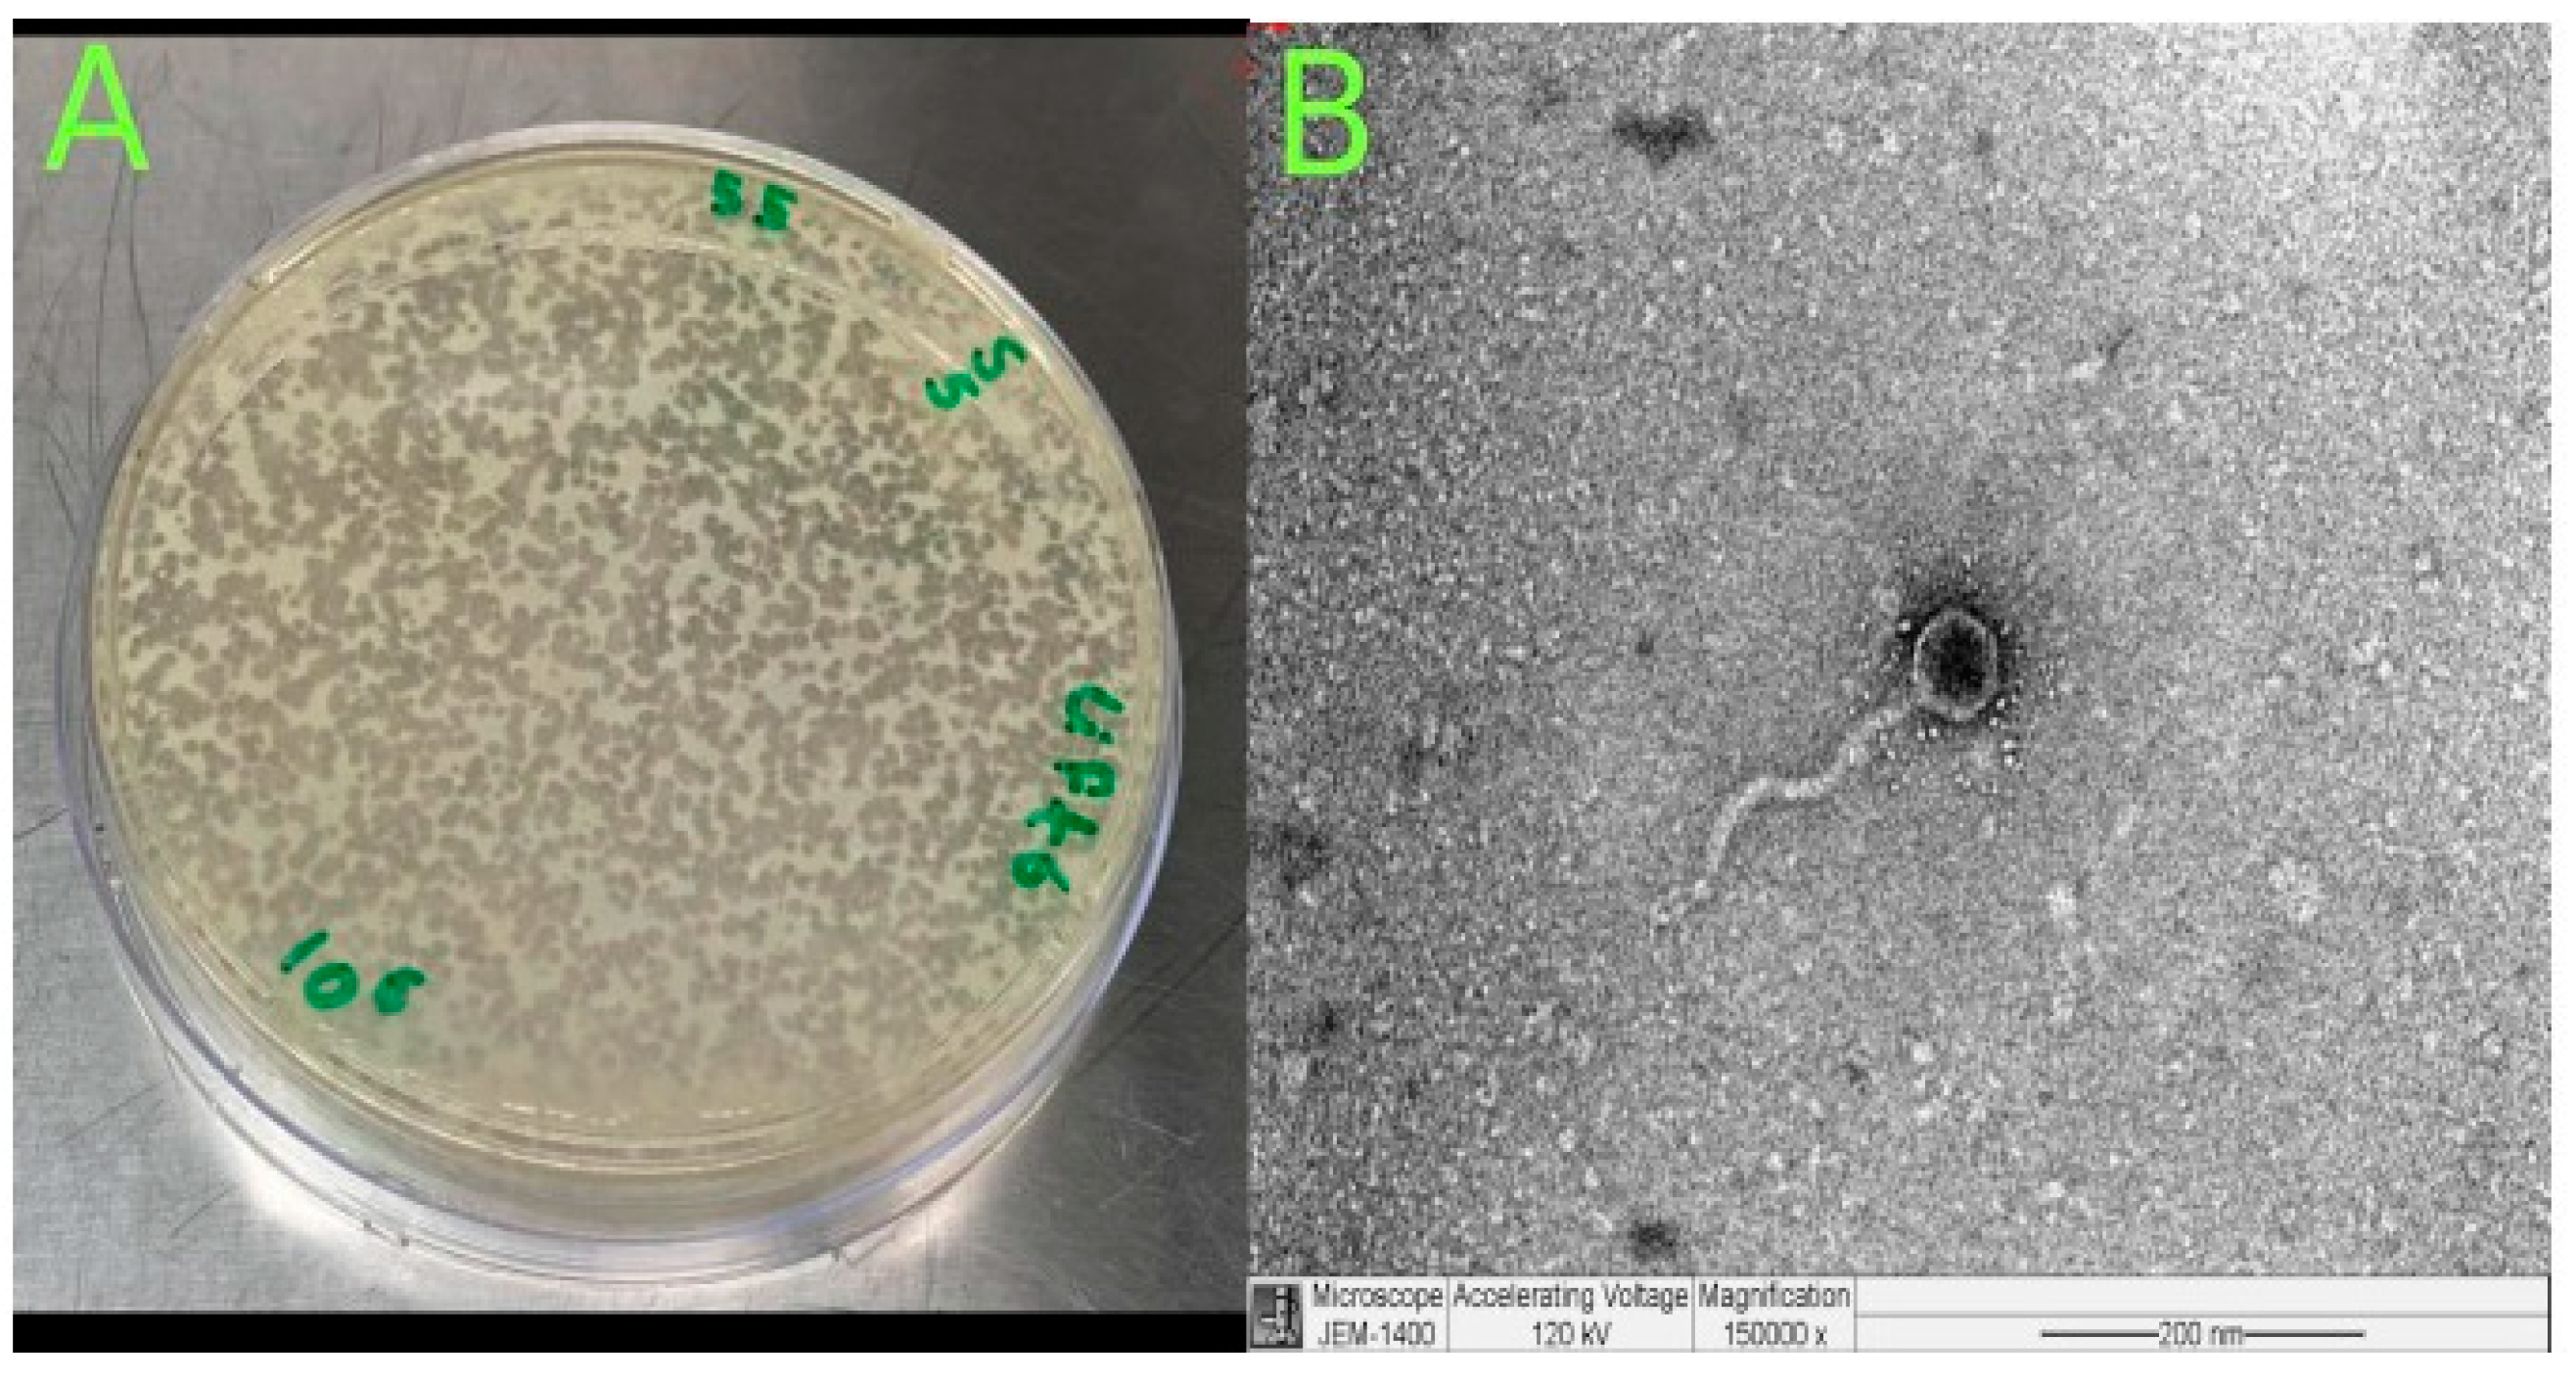

Comprehensive Genomic Analysis of Klebsiella pneumoniae and Its Temperate N-15-like Phage: From Isolation to Functional Annotation
Abstract
1. Introduction
2. Material and Methods
2.1. Culture Conditions and Bacterial Strains
2.2. Bacteriophage Isolation and Purification
2.3. Phage Characterization
2.4. Bacterial DNA Isolation, Sequencing and Bioinformatics Analysis
2.5. Phage DNA Isolation, Sequencing, and Bioinformatics Analysis
2.6. Statistical Analysis
3. Results
3.1. Genome Assembly and Strain Phylogenetic Analysis
3.2. Antimicrobial Susceptibility and Resistome
3.3. Genes Linked to Virulence
3.4. K- and O Serotypes
3.5. Plasmids
3.6. CRISPR-Cas Systems
3.7. Prophage Regions and Viral Sequences
3.8. Klebsiella Phage Kpn_R1 Isolation, Morphology, Assembly and Taxonomy
3.9. General Genome Characteristics
3.10. Predicted Host Range, Evolutionary Relationships, and Genomic Similarity of Klebsiella Phage Kpn_R1
3.11. Klebsiella Phage Kpn_R1 Genome Annotation
4. Discussion
5. Conclusions
Supplementary Materials
Author Contributions
Funding
Institutional Review Board Statement
Informed Consent Statement
Data Availability Statement
Conflicts of Interest
References
- Shah, A.A.; Alwashmi, A.S.S.; Abalkhail, A.; Alkahtani, A.M. Emerging Challenges in Klebsiella pneumoniae: Antimicrobial Resistance and Novel Approach. Microb. Pathog. 2025, 202, 107399. [Google Scholar] [CrossRef] [PubMed]
- Wyres, K.L.; Lam, M.M.C.; Holt, K.E. Population Genomics of Klebsiella pneumoniae. Nat. Rev. Microbiol. 2020, 18, 344–359. [Google Scholar] [CrossRef]
- Effah, C.Y.; Sun, T.; Liu, S.; Wu, Y. Klebsiella pneumoniae: An Increasing Threat to Public Health. Ann. Clin. Microbiol. Antimicrob. 2020, 19, 1. [Google Scholar] [CrossRef] [PubMed]
- Nordmann, P.; Naas, T.; Poirel, L. Global Spread of Carbapenemase-Producing Enterobacteriaceae. Emerg. Infect. Dis. 2011, 17, 1791–1798. [Google Scholar] [CrossRef] [PubMed]
- Riwu, K.H.P.; Effendi, M.H.; Rantam, F.A.; Khairullah, A.R.; Widodo, A. A Review: Virulence Factors of Klebsiella pneumonia as Emerging Infection on the Food Chain. Vet. World 2022, 15, 2172–2179. [Google Scholar] [CrossRef]
- Russo, T.A.; Marr, C.M. Hypervirulent Klebsiella pneumoniae. Clin. Microbiol. Rev. 2019, 32, e00001-19. [Google Scholar] [CrossRef]
- Arnold, B.J.; Huang, I.-T.; Hanage, W.P. Horizontal Gene Transfer and Adaptive Evolution in Bacteria. Nat. Rev. Microbiol. 2022, 20, 206–218. [Google Scholar] [CrossRef]
- Fortier, L.-C.; Sekulovic, O. Importance of Prophages to Evolution and Virulence of Bacterial Pathogens. Virulence 2013, 4, 354–365. [Google Scholar] [CrossRef]
- Ravin, V.; Ravin, N.; Casjens, S.; Ford, M.E.; Hatfull, G.F.; Hendrix, R.W. Genomic Sequence and Analysis of the Atypical Temperate Bacteriophage N15. J. Mol. Biol. 2000, 299, 53–73. [Google Scholar] [CrossRef]
- Ravin, N.V. N15: The Linear Phage–Plasmid. Plasmid 2011, 65, 102–109. [Google Scholar] [CrossRef]
- Ravin, N.V. Mechanisms of Replication and Telomere Resolution of the Linear Plasmid Prophage N15. FEMS Microbiol. Lett. 2003, 221, 1–6. [Google Scholar] [CrossRef] [PubMed]
- Ravin, N.V. Replication and Maintenance of Linear Phage-Plasmid N15. Microbiol. Spectr. 2015, 3, 10-1128. [Google Scholar] [CrossRef] [PubMed]
- Brüssow, H.; Canchaya, C.; Hardt, W.-D. Phages and the Evolution of Bacterial Pathogens: From Genomic Rearrangements to Lysogenic Conversion. Microbiol. Mol. Biol. Rev. 2004, 68, 560–602. [Google Scholar] [CrossRef]
- Casjens, S.R.; Gilcrease, E.B.; Huang, W.M.; Bunny, K.L.; Pedulla, M.L.; Ford, M.E.; Houtz, J.M.; Hatfull, G.F.; Hendrix, R.W. The pKO2 Linear Plasmid Prophage of Klebsiella oxytoca. J. Bacteriol. 2004, 186, 1818–1832. [Google Scholar] [CrossRef] [PubMed]
- Meile, S.; Du, J.; Dunne, M.; Kilcher, S.; Loessner, M.J. Engineering Therapeutic Phages for Enhanced Antibacterial Efficacy. Curr. Opin. Virol. 2022, 52, 182–191. [Google Scholar] [CrossRef]
- Hyman, P.; Abedon, S.T. Bacteriophage Host Range and Bacterial Resistance. In Advances in Applied Microbiology; Elsevier: Amsterdam, The Netherlands, 2010; Volume 70, pp. 217–248. ISBN 978-0-12-380991-9. [Google Scholar]
- Martel, B.; Moineau, S. CRISPR-Cas: An efficient tool for genome engineering of virulent bacteriophages. Nucleic Acids Res. 2014, 42, 9504–9513. [Google Scholar] [CrossRef]
- Citorik, R.J.; Mimee, M.; Lu, T.K. Sequence-Specific Antimicrobials Using Efficiently Delivered RNA-Guided Nucleases. Nat. Biotechnol. 2014, 32, 1141–1145. [Google Scholar] [CrossRef]
- Lu, T.K.; Collins, J.J. Engineered bacteriophage targeting gene networks as adjuvants for antibiotic therapy. Proc. Natl. Acad. Sci. USA 2009, 106, 4629–4634. [Google Scholar] [CrossRef]
- Mahler, M.; Costa, A.R.; Van Beljouw, S.P.B.; Fineran, P.C.; Brouns, S.J.J. Approaches for Bacteriophage Genome Engineering. Trends Biotechnol. 2023, 41, 669–685. [Google Scholar] [CrossRef]
- Kutateladze, M.; Adamia, R. Bacteriophages as potential new therapeutics to replace or supplement antibiotics. Trends Biotechnol. 2010, 28, 591–595. [Google Scholar] [CrossRef]
- Aprea, G.; D’Angelo, A.R.; Prencipe, V.A.; Migliorati, G. Bacteriophage Morphological Characterization by Using Transmission Electron Microscopy. JLS 2015, 10, 214–220. [Google Scholar] [CrossRef]
- Moller, A.G.; Lindsay, J.A.; Read, T.D. Determinants of Phage Host Range in Staphylococcus Species. Appl. Environ. Microbiol. 2019, 85, e00209-19. [Google Scholar] [CrossRef]
- Bolger, A.M.; Lohse, M.; Usadel, B. Trimmomatic: A Flexible Trimmer for Illumina Sequence Data. Bioinformatics 2014, 30, 2114–2120. [Google Scholar] [CrossRef] [PubMed]
- Bankevich, A.; Nurk, S.; Antipov, D.; Gurevich, A.A.; Dvorkin, M.; Kulikov, A.S.; Lesin, V.M.; Nikolenko, S.I.; Pham, S.; Prjibelski, A.D.; et al. SPAdes: A New Genome Assembly Algorithm and Its Applications to Single-Cell Sequencing. J. Comput. Biol. 2012, 19, 455–477. [Google Scholar] [CrossRef] [PubMed]
- Grant, J.R.; Enns, E.; Marinier, E.; Mandal, A.; Herman, E.K.; Chen, C.; Graham, M.; Van Domselaar, G.; Stothard, P. Proksee: In-depth characterization and visualization of bacterial genomes. Nucleic Acids Res. 2023, 51, W484–W492. [Google Scholar] [CrossRef] [PubMed]
- Seemann, T. Prokka: Rapid Prokaryotic Genome Annotation. Bioinformatics 2014, 30, 2068–2069. [Google Scholar] [CrossRef]
- Vernikos, G.S.; Parkhill, J. Interpolated Variable Order Motifs for Identification of Horizontally Acquired DNA: Revisiting the Salmonella Pathogenicity Islands. Bioinformatics 2006, 22, 2196–2203. [Google Scholar] [CrossRef]
- Jain, C.; Rodriguez-R, L.M.; Phillippy, A.M.; Konstantinidis, K.T.; Aluru, S. High Throughput ANI Analysis of 90K Prokaryotic Genomes Reveals Clear Species Boundaries. Nat. Commun. 2018, 9, 5114. [Google Scholar] [CrossRef]
- Alcock, B.P.; Raphenya, A.R.; Lau, T.T.Y.; Tsang, K.K.; Bouchard, M.; Edalatmand, A.; Huynh, W.; Nguyen, A.-L.V.; Cheng, A.A.; Liu, S.; et al. CARD 2020: Antibiotic resistome surveillance with the comprehensive antibiotic resistance database. Nucleic Acids Res. 2019, 48, gkz935. [Google Scholar] [CrossRef]
- Roux, S.; Enault, F.; Hurwitz, B.L.; Sullivan, M.B. VirSorter: Mining viral signal from microbial genomic Data. PeerJ 2015, 3, e985. [Google Scholar] [CrossRef]
- Starikova, E.V.; Tikhonova, P.O.; Prianichnikov, N.A.; Rands, C.M.; Zdobnov, E.M.; Ilina, E.N.; Govorun, V.M. Phigaro: High-throughput prophage sequence annotation. Bioinformatics 2020, 36, 3882–3884. [Google Scholar] [CrossRef]
- Brown, C.L.; Mullet, J.; Hindi, F.; Stoll, J.E.; Gupta, S.; Choi, M.; Keenum, I.; Vikesland, P.; Pruden, A.; Zhang, L. mobileOG-Db: A manually curated database of protein families mediating the life cycle of bacterial mobile genetic elements. Appl. Environ. Microbiol. 2021, 88, e00991-22. [Google Scholar] [CrossRef]
- Grissa, I.; Vergnaud, G.; Pourcel, C. CRISPRFinder: A Web Tool to Identify Clustered Regularly Interspaced Short Palindromic Repeats. Nucleic Acids Res. 2007, 35, W52–W57. [Google Scholar] [CrossRef]
- Wick, R.R.; Heinz, E.; Holt, K.E.; Wyres, K.L. Kaptive Web: User-Friendly Capsule and Lipopolysaccharide Serotype Prediction for Klebsiella Genomes. J. Clin. Microbiol. 2018, 56, e00197-18. [Google Scholar] [CrossRef]
- Jolley, K.A.; Bray, J.E.; Maiden, M.C.J. Open-access bacterial population genomics: BIGSdb software, the PubMLST.Org Website and their applications. Wellcome Open Res. 2018, 3, 124. [Google Scholar] [CrossRef]
- Liu, B.; Zheng, D.; Jin, Q.; Chen, L.; Yang, J. VFDB 2019: A Comparative Pathogenomic Platform with an Interactive Web Interface. Nucleic Acids Res. 2019, 47, D687–D692. [Google Scholar] [CrossRef]
- Seemann, T. Barrnap: Rapid Ribosomal RNA Prediction [Internet]. 2013. Available online: https://github.com/tseemann/barrnap (accessed on 9 March 2025).
- Kumar, S.; Stecher, G.; Li, M.; Knyaz, C.; Tamura, K. MEGA X: Molecular evolutionary genetics analysis across computing platforms. Mol. Biol. Evol. 2018, 35, 1547–1549. [Google Scholar] [CrossRef]
- Mikheenko, A.; Prjibelski, A.; Saveliev, V.; Antipov, D.; Gurevich, A. Versatile genome assembly evaluation with QUAST-LG. Bioinformatics 2018, 34, i142–i150. [Google Scholar] [CrossRef]
- Nayfach, S.; Camargo, A.P.; Schulz, F.; Eloe-Fadrosh, E.; Roux, S.; Kyrpides, N.C. CheckV assesses the quality and completeness of metagenome-assembled viral genomes. Nat. Biotechnol. 2021, 39, 578–585. [Google Scholar] [CrossRef]
- Garneau, J.R.; Depardieu, F.; Fortier, L.-C.; Bikard, D.; Monot, M. PhageTerm: A Tool for Fast and Accurate Determination of Phage Termini and Packaging Mechanism Using next-Generation Sequencing Data. Sci. Rep. 2017, 7, 8292. [Google Scholar] [CrossRef]
- Hockenberry, A.J.; Wilke, C.O. BACPHLIP: Predicting bacteriophage lifestyle from conserved protein domains. PeerJ 2021, 9, e11396. [Google Scholar] [CrossRef] [PubMed]
- Cantu, V.A.; Salamon, P.; Seguritan, V.; Redfield, J.; Salamon, D.; Edwards, R.A.; Segall, A.M. PhANNs, a fast and Accurate tool and web server to classify phage structural proteins. PLoS Comput. Biol. 2020, 16, e1007845. [Google Scholar] [CrossRef]
- Pritchard, L.; Glover, R.H.; Humphris, S.; Elphinstone, J.G.; Toth, I.K. Genomics and taxonomy in diagnostics for food security: Soft-rotting enterobacterial plant pathogens. Anal. Methods 2016, 8, 12–24. [Google Scholar] [CrossRef]
- Gilchrist, C.L.M.; Chooi, Y.-H. Clinker & Clustermap.Js: Automatic generation of gene cluster comparison figures. Bioinformatics 2021, 37, 2473–2475. [Google Scholar] [CrossRef]
- Feldgarden, M.; Brover, V.; Gonzalez-Escalona, N.; Frye, J.G.; Haendiges, J.; Haft, D.H.; Hoffmann, M.; Pettengill, J.B.; Prasad, A.B.; Tillman, G.E.; et al. AMRFinderPlus and the Reference Gene Catalog facilitate examination of the genomic links among antimicrobial resistance, stress response, and virulence. Sci. Rep. 2021, 11, 12728. [Google Scholar] [CrossRef] [PubMed]
- Joensen, K.G.; Scheutz, F.; Lund, O.; Hasman, H.; Kaas, R.S.; Nielsen, E.M.; Aarestrup, F.M. Real-Time Whole-Genome Sequencing for Routine Typing, Surveillance, and Outbreak Detection of Verotoxigenic Escherichia coli. J. Clin. Microbiol. 2014, 52, 1501–1510. [Google Scholar] [CrossRef]
- Grant, J.R.; Stothard, P. The CGView Server: A comparative genomics tool for circular genomes. Nucleic Acids Res. 2008, 36, W181–W184. [Google Scholar] [CrossRef]
- Cook, R.; Brown, N.; Redgwell, T.; Rihtman, B.; Barnes, M.; Clokie, M.; Stekel, D.J.; Hobman, J.; Jones, M.A.; Millard, A. INfrastructure for a PHAge REference Database: Identification of large-scale biases in the current collection of cultured phage genomes. Phage 2021, 2, 214–223. [Google Scholar] [CrossRef]
- Nishimura, Y.; Yoshida, T.; Kuronishi, M.; Uehara, H.; Ogata, H.; Goto, S. ViPTree: The viral proteomic tree server. Bioinformatics 2017, 33, 2379–2380. [Google Scholar] [CrossRef]
- Tamura, K.; Nei, M. Estimation of the number of nucleotide substitutions in the control region of mitochondrial DNA in humans and chimpanzees. Mol. Biol. Evol. 1993, 10, 512–526. [Google Scholar] [CrossRef]
- Felsenstein, J. Confidence Limits on Phylogenies: An Approach Using The Bootstrap. Evolution 1985, 39, 783–791. [Google Scholar] [CrossRef] [PubMed]
- Saitou, N.; Nei, M. The neighbor-joining method: A new method for reconstructing phylogenetic trees. Mol. Biol. Evol. 1987, 4, 406–425. [Google Scholar] [CrossRef]
- Kumar, S.; Stecher, G.; Suleski, M.; Sanderford, M.; Sharma, S.; Tamura, K. MEGA12: Molecular Evolutionary Genetic Analysis version 12 for adaptive and green computing. Mol. Biol. Evol. 2024, 41, msae263. [Google Scholar] [CrossRef]
- Magiorakos, A.-P.; Srinivasan, A.; Carey, R.B.; Carmeli, Y.; Falagas, M.E.; Giske, C.G.; Harbarth, S.; Hindler, J.F.; Kahlmeter, G.; Olsson-Liljequist, B.; et al. Multidrug-resistant, extensively drug-resistant and pandrug-resistant bacteria: An international expert proposal for interim standard definitions for acquired resistance. Clin. Microbiol. Infect. 2012, 18, 268–281. [Google Scholar] [CrossRef]
- Zhang, X.; Chen, D.; Xu, G.; Huang, W.; Wang, X. Molecular epidemiology and drug resistant mechanism in carbapenem-resistant Klebsiella pneumoniae isolated from pediatric patients in Shanghai, China. PLoS ONE 2018, 13, e0194000. [Google Scholar] [CrossRef] [PubMed]
- Poirel, L.; Dortet, L.; Bernabeu, S.; Nordmann, P. Genetic Features of blaNDM-1 -Positive Enterobacteriaceae. Antimicrob. Agents Chemother. 2011, 55, 5403–5407. [Google Scholar] [CrossRef]
- Bulman, Z.P.; Krapp, F.; Pincus, N.B.; Wenzler, E.; Murphy, K.R.; Qi, C.; Ozer, E.A.; Hauser, A.R. Genomic Features Associated with the Degree of Phenotypic Resistance to Carbapenems in Carbapenem-Resistant Klebsiella pneumoniae. mSystems 2021, 6, 10–1128. [Google Scholar] [CrossRef] [PubMed]
- Li, Q.; Yu, X.; Ye, L.; Hou, T.; Liu, Y.; Liu, G.; Wang, Q.; Zhang, D. Hypermucoviscous Multidrug-Resistant Klebsiella variicola Strain LL2208 Isolated from Chinese Longsnout Catfish (Leiocassis longirostris): Highly Similar to Human K. variicola Strains. Pathogens 2024, 13, 647. [Google Scholar] [CrossRef]
- Schneiders, T.; Amyes, S.G.B.; Levy, S.B. Role of AcrR and RamA in Fluoroquinolone Resistance in Clinical Klebsiella pneumoniae Isolates from Singapore. Antimicrob. Agents Chemother. 2003, 47, 2831–2837. [Google Scholar] [CrossRef]
- Yamasaki, E.; Yamada, C.; Jin, X.; Nair, G.B.; Kurazono, H.; Yamamoto, S. Expression of marA is remarkably increased from the early stage of development of fluoroquinolone-resistance in uropathogenic Escherichia coli. J. Infect. Chemother. 2015, 21, 105–109. [Google Scholar] [CrossRef]
- Moosavian, M.; Khoshkholgh Sima, M.; Ahmad Khosravi, N.; Abbasi Montazeri, E. Detection of OqxAB Efflux Pumps, a Multidrug-Resistant Agent in Bacterial Infection in Patients Referring to Teaching Hospitals in Ahvaz, Southwest of Iran. Int. J. Microbiol. 2021, 2021, 2145176. [Google Scholar] [CrossRef] [PubMed]
- Sionov, R.V.; Steinberg, D. Targeting the Holy Triangle of Quorum Sensing, Biofilm Formation, and Antibiotic Resistance in Pathogenic Bacteria. Microorganisms 2022, 10, 1239. [Google Scholar] [CrossRef]
- Zhou, Y.; Ai, W.; Guo, Y.; Wu, X.; Wang, B.; Xu, Y.; Rao, L.; Zhao, H.; Wang, X.; Yu, F. Co-Occurrence of Rare ArmA-, RmtB-, and KPC-2–Encoding Multidrug-Resistant Plasmids and Hypervirulence iuc Operon in ST11-KL47 Klebsiella pneumoniae. Microbiol. Spectr. 2022, 10, e02371-21. [Google Scholar] [CrossRef] [PubMed]
- Sheng, J.; Cave, R.; Ter-Stepanyan, M.M.; Kotsinyan, N.; Chen, J.; Zhang, L.; Jiang, T.; Mkrtchyan, H.V. Whole-Genome Sequencing and Comparative Genomics Analysis of a Newly Emerged Multidrug-Resistant Klebsiella pneumoniae Isolate of ST967. Microbiol. Spectr. 2023, 11, e04011-22. [Google Scholar] [CrossRef]
- Gravey, F.; Sévin, C.; Castagnet, S.; Foucher, N.; Maillard, K.; Tapprest, J.; Léon, A.; Langlois, B.; Le Hello, S.; Petry, S. Antimicrobial resistance and genetic diversity of Klebsiella pneumoniae strains from different clinical sources in horses. Front. Microbiol. 2024, 14, 1334555. [Google Scholar] [CrossRef]
- Golkar, T.; Zieliński, M.; Berghuis, A.M. Look and Outlook on Enzyme-Mediated Macrolide Resistance. Front. Microbiol. 2018, 9, 1942. [Google Scholar] [CrossRef] [PubMed]
- Pawlowski, A.C.; Stogios, P.J.; Koteva, K.; Skarina, T.; Evdokimova, E.; Savchenko, A.; Wright, G.D. The evolution of substrate discrimination in macrolide antibiotic resistance enzymes. Nat. Commun. 2018, 9, 112. [Google Scholar] [CrossRef]
- Talat, A.; Khan, F.; Khan, A.U. Genome analyses of colistin-resistant high-risk blaNDM-5 producing Klebsiella pneumoniae ST147 and Pseudomonas aeruginosa ST235 and ST357 in clinical settings. BMC Microbiol. 2024, 24, 174. [Google Scholar] [CrossRef]
- Venkatesan, M.; Fruci, M.; Verellen, L.A.; Skarina, T.; Mesa, N.; Flick, R.; Pham, C.; Mahadevan, R.; Stogios, P.J.; Savchenko, A. Molecular mechanism of plasmid-borne resistance to sulfonamide antibiotics. Nat. Commun. 2023, 14, 4031. [Google Scholar] [CrossRef]
- Wang, W.; Baloch, Z.; Peng, Z.; Hu, Y.; Xu, J.; Fanning, S.; Li, F. Genomic characterization of a large plasmid containing a bla NDM-1 gene carried on Salmonella enterica serovar Indiana C629 isolate from China. BMC Infect. Dis. 2017, 17, 479. [Google Scholar] [CrossRef]
- Tomich, A.D.; Klontz, E.H.; Deredge, D.; Barnard, J.P.; McElheny, C.L.; Eshbach, M.L.; Weisz, O.A.; Wintrode, P.; Doi, Y.; Sundberg, E.J.; et al. Small-Molecule Inhibitor of FosA Expands Fosfomycin Activity to Multidrug-Resistant Gram-Negative Pathogens. Antimicrob. Agents Chemother. 2019, 63, e01524-18. [Google Scholar] [CrossRef] [PubMed]
- Liu, X.; Gong, L.; Liu, E.; Li, C.; Wang, Y.; Liang, J. Characterization of the Disinfectant Resistance Genes qacEΔ1 and cepA in Carbapenem-Resistant Klebsiella pneumoniae Isolates. Am. J. Trop. Med. Hyg. 2024, 110, 136–141. [Google Scholar] [CrossRef] [PubMed]
- Wareth, G.; Linde, J.; Hammer, P.; Pletz, M.W.; Neubauer, H.; Sprague, L.D. WGS-Based Phenotyping and Molecular Characterization of the Resistome, Virulome and Plasmid Replicons in Klebsiella pneumoniae Isolates from Powdered Milk Produced in Germany. Microorganisms 2022, 10, 564. [Google Scholar] [CrossRef]
- Shankar, C.; Vasudevan, K.; Jacob, J.J.; Baker, S.; Isaac, B.J.; Neeravi, A.R.; Sethuvel, D.P.M.; George, B.; Veeraraghavan, B. Hybrid Plasmids Encoding Antimicrobial Resistance and Virulence Traits Among Hypervirulent Klebsiella pneumoniae ST2096 in India. Front. Cell. Infect. Microbiol. 2022, 12, 875116. [Google Scholar] [CrossRef]
- Shukla, S.; Desai, S.; Bagchi, A.; Singh, P.; Joshi, M.; Joshi, C.; Patankar, J.; Maheshwari, G.; Rajni, E.; Shah, M.; et al. Diversity and Distribution of β-Lactamase Genes Circulating in Indian Isolates of Multidrug-Resistant Klebsiella pneumoniae. Antibiotics 2023, 12, 449. [Google Scholar] [CrossRef] [PubMed]
- Stercz, B.; Farkas, F.B.; Tóth, Á.; Gajdács, M.; Domokos, J.; Horváth, V.; Ostorházi, E.; Makra, N.; Kocsis, B.; Juhász, J.; et al. The influence of antibiotics on transitory resistome during gut colonization with CTX-M-15 and OXA-162 producing Klebsiella pneumoniae ST15. Sci. Rep. 2021, 11, 6335. [Google Scholar] [CrossRef]
- Salloum, T.; Arabaghian, H.; Alousi, S.; Abboud, E.; Tokajian, S. Genome sequencing and comparative analysis of an NDM-1-producing Klebsiella pneumoniae ST15 isolated from a refugee patient. Pathog. Glob. Health 2017, 111, 166–175. [Google Scholar] [CrossRef]
- Hetland, M.A.K.; Hawkey, J.; Bernhoff, E.; Bakksjø, R.-J.; Kaspersen, H.; Rettedal, S.I.; Sundsfjord, A.; Holt, K.E.; Löhr, I.H. Within–patient and global evolutionary dynamics of Klebsiella pneumoniae ST17. Microb. Genom. 2023, 9, 001005. [Google Scholar] [CrossRef]
- Ravin, N.; Lane, D. Partition of the Linear Plasmid N15: Interactions of N15 Partition Functions with the sop Locus of the F Plasmid. J. Bacteriol. 1999, 181, 6898–6906. [Google Scholar] [CrossRef]
- Zinke, M.; Schröder, G.F.; Lange, A. Major tail proteins of bacteriophages of the order Caudovirales. J. Biol. Chem. 2022, 298, 101472. [Google Scholar] [CrossRef]
- Lo, C.-Y.; Gao, Y. DNA Helicase–Polymerase Coupling in Bacteriophage DNA Replication. Viruses 2021, 13, 1739. [Google Scholar] [CrossRef] [PubMed]
- Lee, S.; Lewis, D.E.A.; Adhya, S. The Developmental Switch in Bacteriophage λ: A Critical Role of the Cro Protein. J. Mol. Biol. 2018, 430, 58–68. [Google Scholar] [CrossRef] [PubMed]
- Cahill, J.; Young, R. Phage Lysis: Multiple Genes for Multiple Barriers. In Advances in Virus Research; Elsevier: Amsterdam, The Netherlands, 2019; Volume 103, pp. 33–70. ISBN 978-0-12-817722-8. [Google Scholar]
- Jiang, S.; Chen, C.; Huang, W.; He, Y.; Du, X.; Wang, Y.; Ou, H.; Deng, Z.; Xu, C.; Jiang, L.; et al. A widespread phage-encoded kinase enables evasion of multiple host antiphage defence systems. Nat. Microbiol. 2024, 9, 3226–3239. [Google Scholar] [CrossRef] [PubMed]
- Goldsmith, D.B.; Crosti, G.; Dwivedi, B.; McDaniel, L.D.; Varsani, A.; Suttle, C.A.; Weinbauer, M.G.; Sandaa, R.-A.; Breitbart, M. Development of phoH as a Novel Signature Gene for Assessing Marine Phage Diversity. Appl. Environ. Microbiol. 2011, 77, 7730–7739. [Google Scholar] [CrossRef]
- Groth, A.C.; Calos, M.P. Phage Integrases: Biology and Applications. J. Mol. Biol. 2004, 335, 667–678. [Google Scholar] [CrossRef]
- Deneke, J.; Ziegelin, G.; Lurz, R.; Lanka, E. The protelomerase of temperate Escherichia coli phage N15 has cleaving-joining activity. Proc. Natl. Acad. Sci. USA 2000, 97, 7721–7726. [Google Scholar] [CrossRef]
- Holt, K.E.; Wertheim, H.; Zadoks, R.N.; Baker, S.; Whitehouse, C.A.; Dance, D.; Jenney, A.; Connor, T.R.; Hsu, L.Y.; Severin, J.; et al. Genomic analysis of diversity, population structure, virulence, and antimicrobial resistance in Klebsiella pneumoniae, an urgent threat to public health. Proc. Natl. Acad. Sci. USA 2015, 112, E3574–E3581. [Google Scholar] [CrossRef]
- Logan, L.K.; Weinstein, R.A. The Epidemiology of Carbapenem-Resistant Enterobacteriaceae: The Impact and Evolution of a Global Menace. J. Infect. Dis. 2017, 215, S28–S36. [Google Scholar] [CrossRef]
- Yong, D.; Toleman, M.A.; Giske, C.G.; Cho, H.S.; Sundman, K.; Lee, K.; Walsh, T.R. Characterization of a New Metallo-β-Lactamase Gene, bla NDM-1, and a Novel Erythromycin Esterase Gene Carried on a Unique Genetic Structure in Klebsiella pneumoniae Sequence Type 14 from India. Antimicrob. Agents Chemother. 2009, 53, 5046–5054. [Google Scholar] [CrossRef]
- Sreekumaran, S.; Priya, V.K.; Premnath, M.; Prathiush, P.R.; Anisha, M.N.; Mathew, J.; Jayachandran, K.; Radhakrishnan, E.K. Novel in-genome based analysis demonstrates the evolution of OmpK37, antimicrobial resistance gene from a potentially pathogenic pandrug resistant Klebsiella pneumoniae MS1 isolated from healthy broiler feces. Sci. Total Environ. 2024, 930, 172713. [Google Scholar] [CrossRef]
- Di Pilato, V.; Henrici De Angelis, L.; Aiezza, N.; Baccani, I.; Niccolai, C.; Parisio, E.M.; Giordano, C.; Camarlinghi, G.; Barnini, S.; Forni, S.; et al. Resistome and virulome accretion in an NDM-1-producing ST147 sublineage of Klebsiella pneumoniae associated with an outbreak in Tuscany, Italy: A genotypic and phenotypic characterisation. Lancet Microbe 2022, 3, e224–e234. [Google Scholar] [CrossRef] [PubMed]
- Huang, J.; Alhejaili, A.Y.; Alkherd, U.H.; Milner, M.; Zhou, G.; Alzahrani, D.; Banzhaf, M.; Alzaidi, A.A.; Rajeh, A.A.; Al-Otaiby, M.A.; et al. The dissemination of multidrug-resistant and hypervirulent Klebsiella pneumoniae clones across the Kingdom of Saudi Arabia. Emerg. Microbes Infect. 2024, 13, 2427793. [Google Scholar] [CrossRef]
- Sonnevend, Á.; Abdulrazzaq, N.; Ghazawi, A.; Thomsen, J.; Bharathan, G.; Makszin, L.; Rizvi, T.A.; Pál, T. The first nationwide surveillance of carbapenem-resistant Enterobacterales in the United Arab Emirates—Increased association of Klebsiella pneumoniae CC14 clone with Emirati patients. Int. J. Infect. Dis. 2022, 120, 103–112. [Google Scholar] [CrossRef]
- Idrees, E.K.; Aldriwesh, M.G.; Alkhulaifi, M.M.; Alghoribi, M.F. Systematic review of multidrug-resistant Klebsiella pneumoniae in the Arabian Peninsula: Molecular epidemiology and resistance patterns. Front. Microbiol. 2025, 16, 1489317. [Google Scholar] [CrossRef] [PubMed]
- Kareem, S.M.; Al-Kadmy, I.M.S.; Kazaal, S.S.; Mohammed Ali, A.N.; Aziz, S.N.; Makharita, R.R.; Algammal, A.M.; Al-Rejaie, S.; Behl, T.; Batiha, G.E.-S.; et al. Detection of gyrA and parC Mutations and Prevalence of Plasmid-Mediated Quinolone Resistance Genes in Klebsiella pneumoniae. Infect. Drug Resist. 2021, 14, 555–563. [Google Scholar] [CrossRef]
- Doi, Y.; Wachino, J.; Arakawa, Y. Aminoglycoside Resistance. Infect. Dis. Clin. North Am. 2016, 30, 523–537. [Google Scholar] [CrossRef]
- Chopra, I.; Roberts, M. Tetracycline Antibiotics: Mode of Action, Applications, Molecular Biology, and Epidemiology of Bacterial Resistance. Microbiol. Mol. Biol. Rev. 2001, 65, 232–260. [Google Scholar] [CrossRef] [PubMed]
- Nishino, K.; Yamasaki, S.; Nakashima, R.; Zwama, M.; Hayashi-Nishino, M. Function and Inhibitory Mechanisms of Multidrug Efflux Pumps. Front. Microbiol. 2021, 12, 737288. [Google Scholar] [CrossRef]
- Huovinen, P.; Sundström, L.; Swedberg, G.; Sköld, O. Trimethoprim and Sulfonamide Resistance. Antimicrob. Agents Chemother. 1995, 39, 279–289. [Google Scholar] [CrossRef]
- Falagas, M.E.; Kastoris, A.C.; Kapaskelis, A.M.; Karageorgopoulos, D.E. Fosfomycin for the treatment of multidrug-resistant, including extended-spectrum β-lactamase producing, Enterobacteriaceae infections: A systematic review. Lancet Infect. Dis. 2010, 10, 43–50. [Google Scholar] [CrossRef]
- Poirel, L.; Jayol, A.; Nordmann, P. Polymyxins: Antibacterial Activity, Susceptibility Testing, and Resistance Mechanisms Encoded by Plasmids or Chromosomes. Clin. Microbiol. Rev. 2017, 30, 557–596. [Google Scholar] [CrossRef] [PubMed]
- Cervinkova, D.; Babak, V.; Marosevic, D.; Kubikova, I.; Jaglic, Z. The Role of the qacA Gene in Mediating Resistance to Quaternary Ammonium Compounds. Microbial. Drug Resistance 2013, 19, 160–167. [Google Scholar] [CrossRef]
- Rendón, M.A.; Saldaña, Z.; Erdem, A.L.; Monteiro-Neto, V.; Vázquez, A.; Kaper, J.B.; Puente, J.L.; Girón, J.A. Commensal and pathogenic Escherichia coli use a common pilus adherence factor for epithelial cell colonization. Proc. Natl. Acad. Sci. USA 2007, 104, 10637–10642. [Google Scholar] [CrossRef] [PubMed]
- Bachman, M.A.; Oyler, J.E.; Burns, S.H.; Caza, M.; Lépine, F.; Dozois, C.M.; Weiser, J.N. Klebsiella pneumoniae Yersiniabactin Promotes Respiratory Tract Infection Through Evasion of Lipocalin 2. Infect. Immun. 2011, 79, 3309–3316. [Google Scholar] [CrossRef]
- Smani, Y.; Fàbrega, A.; Roca, I.; Sánchez-Encinales, V.; Vila, J.; Pachón, J. Role of OmpA in the Multidrug Resistance Phenotype of Acinetobacter Baumannii. Antimicrob. Agents Chemother. 2014, 58, 1806–1808. [Google Scholar] [CrossRef]
- Makarova, K.S.; Wolf, Y.I.; Alkhnbashi, O.S.; Costa, F.; Shah, S.A.; Saunders, S.J.; Barrangou, R.; Brouns, S.J.J.; Charpentier, E.; Haft, D.H.; et al. An updated evolutionary classification of CRISPR–Cas systems. Nat. Rev. Microbiol. 2015, 13, 722–736. [Google Scholar] [CrossRef] [PubMed]
- Carattoli, A.; Seiffert, S.N.; Schwendener, S.; Perreten, V.; Endimiani, A. Differentiation of IncL and IncM Plasmids Associated with the Spread of Clinically Relevant Antimicrobial Resistance. PLoS ONE 2015, 10, e0123063. [Google Scholar] [CrossRef]
- Cascales, E.; Buchanan, S.K.; Duché, D.; Kleanthous, C.; Lloubès, R.; Postle, K.; Riley, M.; Slatin, S.; Cavard, D. Colicin Biology. Microbiol. Mol. Biol. Rev. 2007, 71, 158–229. [Google Scholar] [CrossRef]
- Hertwig, S.; Klein, I.; Schmidt, V.; Beck, S.; Hammerl, J.A.; Appel, B. Sequence Analysis of the Genome of the Temperate Yersinia Enterocolitica Phage PY54. J. Mol. Biol. 2003, 331, 605–622. [Google Scholar] [CrossRef]
- Kelly, A.; Arrowsmith, T.J.; Went, S.C.; Blower, T.R. Toxin–antitoxin systems as mediators of phage defence and the implications for abortive infection. Curr. Opin. Microbiol. 2023, 73, 102293. [Google Scholar] [CrossRef]
- Yamaguchi, Y.; Park, J.-H.; Inouye, M. Toxin-Antitoxin Systems in Bacteria and Archaea. Annu. Rev. Genet. 2011, 45, 61–79. [Google Scholar] [CrossRef] [PubMed]
- Fokine, A.; Kostyuchenko, V.A.; Efimov, A.V.; Kurochkina, L.P.; Sykilinda, N.N.; Robben, J.; Volckaert, G.; Hoenger, A.; Chipman, P.R.; Battisti, A.J.; et al. A Three-dimensional Cryo-electron Microscopy Structure of the Bacteriophage ϕKZ Head. J. Mol. Biol. 2005, 352, 117–124. [Google Scholar] [CrossRef] [PubMed]
- Hatfull, G.F.; Cresawn, S.G.; Hendrix, R.W. Comparative genomics of the mycobacteriophages: Insights into bacteriophage evolution. Res. Microbiol. 2008, 159, 332–339. [Google Scholar] [CrossRef]
- Howard-Varona, C.; Hargreaves, K.R.; Abedon, S.T.; Sullivan, M.B. Lysogeny in nature: Mechanisms, impact and ecology of temperate phages. ISME J. 2017, 11, 1511–1520. [Google Scholar] [CrossRef] [PubMed]
- Sutton, M.D.; Smith, B.T.; Godoy, V.G.; Walker, G.C. THE SOS RESPONSE: Recent Insights into umuDC -Dependent Mutagenesis and DNA Damage Tolerance. Annu. Rev. Genet. 2000, 34, 479–497. [Google Scholar] [CrossRef]
- Gutierrez, A.; Laureti, L.; Crussard, S.; Abida, H.; Rodríguez-Rojas, A.; Blázquez, J.; Baharoglu, Z.; Mazel, D.; Darfeuille, F.; Vogel, J.; et al. β-lactam antibiotics promote bacterial mutagenesis via an RpoS-mediated reduction in replication fidelity. Nat. Commun. 2013, 4, 1610. [Google Scholar] [CrossRef]

| Antimicrobial Class | Antimicrobial Agent | MIC (μg/mL) | Gene | Resistance Mechanism | Notes | References |
|---|---|---|---|---|---|---|
| Beta-lactams | Penicillin | ≥16 | blaSHV-11 blaNDM-1 OmpK37, MdtQ | Beta-lactamase carbapenemase porin mutation | High resistance due to beta-lactamases and reduced permeability. | [57,58,59,60] |
| Cephalosporin | Ceftriaxone | ≥32 | ||||
| Carbapenem | Meropenem | ≥8 | blaNDM-1 OmpK37, MdtQ | Carbapenemase porin mutation | Carbapenem resistance due to carbapenemase and reduced permeability | [27,28,29] |
| Monobactam | Aztreonam | ≥32 | OmpK37, MdtQ | Porin mutation | Resistance due to reduced permeability | [28,29] |
| Fluoroquinolones | Ciprofloxacin | ≥4 | oqxA, acrA, marA, rsmA | Efflux pumps | High resistance due to efflux and target mutations | [61,62,63,64] |
| Levofloxacin | ≥8 | |||||
| Aminoglycosides | Gentamicin | ≥16 | armA aadA2 | 16S rRNA methyltransferase aminoglycoside-modifying enzyme | High-level resistance due to target modification and enzymatic inactivation | [65] |
| Amikacin | ≥64 | armA | 16S rRNA methyltransferase | Resistance due to target modification | [65] | |
| Tetracyclines | Tetracycline | ≥16 | tet(A), K. pneumoniae KpnF | Efflux pump | Resistance due to efflux-mediated resistance | [66,67] |
| Tigecycline | ≥2 | |||||
| Macrolides | Erythromycin | ≥8 | msrE mphE KpnF, KpnG, KpnH | ABC-F protein macrolide phosphotransferase efflux pumps | Resistance due to efflux and enzymatic inactivation. | [60,68,69] |
| Azithromycin | ≥16 | |||||
| Peptide Antibiotics | Colistin (Polymyxin E) | ≥4 | ArnT, eptB OmpA | Phosphoethanolamine transferase Porin | Resistance due to target modification and reduced permeability | [70] |
| Polymyxin B | ≥4 | |||||
| Sulfonamides | Sulfamethoxazole | ≥256 | sul1 | Sulfonamide-resistant dihydropteroate synthase | High resistance due to target replacement | [71] |
| Diaminopyrimidines | Trimethoprim | ≥16 | dfrA12 | Trimethoprim-resistant dihydrofolate reductase | Resistance due to target replacement | [66] |
| Phenicols | Chloramphenicol | ≥32 | acrA, rsmA | Efflux pumps | Resistance due to efflux mechanisms | [62,64] |
| Bleomycin | Bleomycin | bleMBL | BRPMBL (Bleomycin Resistance Protein) | Resistance due to target alteration | [72] | |
| Rifamycins | Rifampin | ≥8 | KpnF, KpnE, marA | Efflux pumps | Resistance due to efflux mechanisms | [60] |
| Fosfomycin | Fosfomycin | ≥64 | fosA5 | Fosfomycin thiol transferase | Resistance due to enzymatic inactivation | [73] |
| Disinfectants/ Antiseptics | Quaternary ammonium compounds | ≥50 | qacEΔ1, leuO | Efflux pump, transcription regulator | Resistance due to efflux mechanisms | [74] |
| Gene | % Coverage | % Identity | Product | Virulence Factor | Accession |
|---|---|---|---|---|---|
| ecpR | 98.31 | 86.58 | regulator protein [EcpR] | E. coli common pilus (ECP) | NP_286011 |
| ecpA | 99.32 | 90.07 | E. coli common pilus structural subunit [EcpA] | NP_286010 | |
| ecpB | 100.00 | 87.89 | E. coli common pilus chaperone [EcpB] | NP_286009 | |
| ecpC | 99.96 | 87.42 | E. coli common pilus usher [EcpC] | NP_286008 | |
| ecpD | 100.00 | 88.81 | polymerized tip adhesin of ECP fibers [EcpD] | NP_286007 | |
| ecpE | 99.74 | 85.28 | E. coli common pilus chaperone [EcpE] | NP_286006 | |
| fyuA | 100.00 | 99.95 | pesticin/yersiniabactin receptor protein [FyuA] | Yersiniabactin biosynthesis | NP_405467 |
| ybtE | 100.00 | 99.75 | siderophore biosynthetic protein [YbtE] | NP_405468 | |
| ybtT | 100.00 | 99.75 | Yersiniabactin [YbtT] | NP_405469 | |
| 100.00 | 99.73 | Yersiniabactin [YbtU] | NP_405470 | ||
| irp1 | 100.00 | 99.82 | Yersiniabactin [Irp1] | NP_405471 | |
| irp2 | 100.00 | 99.75 | Yersiniabactin [Irp2] | NP_405472 | |
| ybtA | 100.00 | 99.79 | Yersiniabactin transcriptional regulator [YbtA] | NP_405473 | |
| ybtP | 100.00 | 99.72 | lipoprotein inner membrane ABC-transporter [YbtP] | NP_405474 | |
| ybtQ | 100.00 | 99.89 | inner membrane ABC-transporter [YbtQ] | NP_405475 | |
| ybtX | 100.00 | 97.74 | putative signal transducer [YbtX] | NP_405476 | |
| ybtS | 100.00 | 97.62 | salicylate synthase [Irp9] | NP_405477 | |
| fepC | 94.61 | 81.22 | ferrienterobactin ABC transporter ATPase [FepC] | Enterobactin biosynthesis | NP_752606 |
| fepG | 88.72 | 80.07 | iron-enterobactin ABC transporter permease [FepG] | NP_752607 | |
| entB | 99.18 | 82.65 | Isochorismatase [EntB] | NP_752613 | |
| entA | 99.33 | 80.00 | 23-dihydro-23-dihydroxybenzoate dehydrogenase [EntA] | NP_752614 | |
| ompA | 100.00 | 83.75 | outer membrane protein A [OmpA] | Immune evasion | AAF37887 |
| Strand | Plasmid | Coverage % | Identity % | Product | Accession/References |
|---|---|---|---|---|---|
| + | Col440I_1 | 100 | 96.49 | Col440I_1__CP023920.1 | CP023920.1 [75] |
| − | IncHI1B_1_pNDM-MAR | 100 | 100.00 | IncHI1B_1_pNDM-MAR_JN420336 (NDM carbapenemase) | JN420336 [76] |
| + | Col(BS512)_1 | 100 | 100.00 | Col(BS512)_1__NC_010656 | NC_010656 [77] |
| − | ColpVC_1 | 100 | 88.60 | ColpVC_1__JX133088 | JX133088 [78] |
| − | IncFIB(pKPHS1)_1_pKPHS1 | 100 | 95.54 | IncFIB(pKPHS1)_1_pKPHS1_CP003223 | CP003223 [79] |
| + | IncFIB(K)_1_Kpn3 | 100 | 91.07 | IncFIB(K)_1_Kpn3_JN233704 | JN233704 [80] |
| Species | Hits | Average Matching Hashes | Average p-Value of Hits | Average Genetic Distances |
|---|---|---|---|---|
| Erwinia | 1 hit | 5 | 4.36 × 10−27 | 0.22 |
| Yersinia | 2 hits | 5 | 5.09 × 10−27 | 0.22 |
| Klebsiella | 33 hits | 215.3 | 3.38 × 10−111 | 0.06 |
| Salmonella | 13 hits | 4.15 | 1.21 × 10−21 | 0.23 |
| Campylobacter | 1 hit | 4 | 1.50 × 10−21 | 0.23 |
| Genus | Hits | Average Matching Hashes | Average p-Value of Hits | Average Genetic Distances |
|---|---|---|---|---|
| Unclassified | 14 hits | 149.57 | 3.11 × 10−28 | 0.1 |
| Epseptimavirus | 15 hits | 4.27 | 1.13 × 10−21 | 0.23 |
| Sugarlandvirus | 20 hits | 250.8 | 0.00 × 10+00 | 0.04 |
| Loughboroughvirus | 1 hit | 4 | 2.31 × 10−22 | 0.23 |
| Category | Number of Proteins | Percentage | Key Examples | References |
|---|---|---|---|---|
| Partioning and maintainance | 3 | 1.42 | SopA/ParB proteins | [81] |
| Unknown | 102 | 48.34 | Proteins labeled as “hypothetical”, “uncharacterized”, or with DUF domains | - |
| Tail, head, connector, and packaging | 38 | 18.01 | Tail, tail fibers, tail tape measure, Terminase (TerL/S), scaffolding protein, prohead protease, capsid, head, host division inhibitor, connector | [82] |
| DNA, RNA, and nucleotide metabolism | 25 | 11.85 | DNA polymerase, helicase, ribonucleotide reductase, exonuclease, thymidylate synthase | [83] |
| Transcription regulation | 6 | 2.84 | Cro/CI regulator, LexA, antitermination protein Q, sigma-54 factor, DNA methyltransferase, receptor-binding protein | [84] |
| Lysis | 3 | 1.42 | Holin, endolysin | [85] |
| Moron, auxiliary metabolic genes, and host takeover | 13 | 6.16 | Glutamate 5-kinase, PhoH-like protein, thioredoxin, tRNA-like domains | [86,87] |
| Integration and excision | 2 | 0.95 | Integrase, excisionase Xis | [88] |
| others | 18 | 8.53 | - | - |
| Protelomeras | 1 | 0.47 | Protelomeras | [89] |
| Total | 211 | 100 | - | - |
Disclaimer/Publisher’s Note: The statements, opinions and data contained in all publications are solely those of the individual author(s) and contributor(s) and not of MDPI and/or the editor(s). MDPI and/or the editor(s) disclaim responsibility for any injury to people or property resulting from any ideas, methods, instructions or products referred to in the content. |
© 2025 by the authors. Licensee MDPI, Basel, Switzerland. This article is an open access article distributed under the terms and conditions of the Creative Commons Attribution (CC BY) license (https://creativecommons.org/licenses/by/4.0/).
Share and Cite
Yahya, R.; Albaqami, A.; Alzahrani, A.; Althubaiti, S.M.; Alhariri, M.; Alrashidi, E.T.; Alhazmi, N.; Al-Matary, M.A.; Alharbi, N. Comprehensive Genomic Analysis of Klebsiella pneumoniae and Its Temperate N-15-like Phage: From Isolation to Functional Annotation. Microorganisms 2025, 13, 908. https://doi.org/10.3390/microorganisms13040908
Yahya R, Albaqami A, Alzahrani A, Althubaiti SM, Alhariri M, Alrashidi ET, Alhazmi N, Al-Matary MA, Alharbi N. Comprehensive Genomic Analysis of Klebsiella pneumoniae and Its Temperate N-15-like Phage: From Isolation to Functional Annotation. Microorganisms. 2025; 13(4):908. https://doi.org/10.3390/microorganisms13040908
Chicago/Turabian StyleYahya, Reham, Aljawharah Albaqami, Amal Alzahrani, Suha M. Althubaiti, Moayad Alhariri, Eisa T. Alrashidi, Nada Alhazmi, Mohammed A. Al-Matary, and Najwa Alharbi. 2025. "Comprehensive Genomic Analysis of Klebsiella pneumoniae and Its Temperate N-15-like Phage: From Isolation to Functional Annotation" Microorganisms 13, no. 4: 908. https://doi.org/10.3390/microorganisms13040908
APA StyleYahya, R., Albaqami, A., Alzahrani, A., Althubaiti, S. M., Alhariri, M., Alrashidi, E. T., Alhazmi, N., Al-Matary, M. A., & Alharbi, N. (2025). Comprehensive Genomic Analysis of Klebsiella pneumoniae and Its Temperate N-15-like Phage: From Isolation to Functional Annotation. Microorganisms, 13(4), 908. https://doi.org/10.3390/microorganisms13040908

